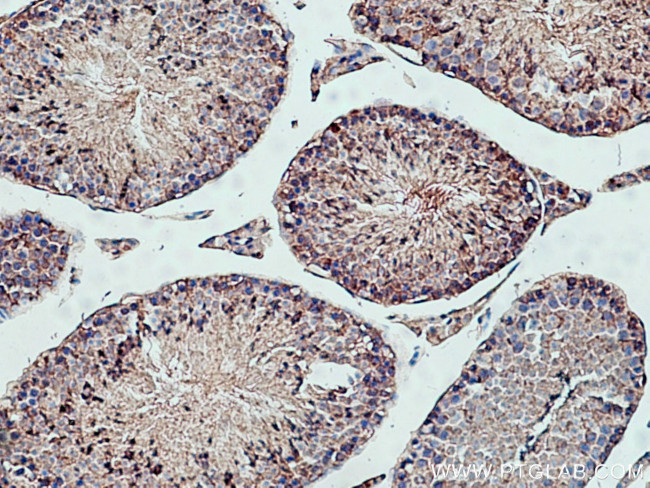
PPP6C Antibody in Immunohistochemistry (Paraffin) (IHC (P))

Search
Proteintech
PPP6C Polyclonal Antibody
{{$productOrderCtrl.translations['antibody.pdp.commerceCard.promotion.promotions']}}
{{$productOrderCtrl.translations['antibody.pdp.commerceCard.promotion.viewpromo']}}
{{$productOrderCtrl.translations['antibody.pdp.commerceCard.promotion.promocode']}}: {{promo.promoCode}} {{promo.promoTitle}} {{promo.promoDescription}}. {{$productOrderCtrl.translations['antibody.pdp.commerceCard.promotion.learnmore']}}
产品信息
15852-1-AP
种属反应
已发表种属
宿主/亚型
分类
类型
抗原
偶联物
形式
浓度
规格
纯化类型
保存液
内含物
保存条件
运输条件
产品详细信息
Immunogen sequence: MAPLDLDKY VEIARLCKYL PENDLKRLCD YVCDLLLEES NVQPVSTPVT VCGDIHGQFY DLCELFRTGG QVPDTNYIFM GDFVDRGYYS LETFTYLLAL KAKWPDRITL LRGNHESRQI TQVYGFYDEC QTKYGNANAW RYCTKVFDML TVAALIDEQI LCVHGGLSPD IKTLDQIRTI ERNQEIPHKG AFCDLVWSDP EDVDTWAISP RGAGWLFGAK VTNEFVHINN LKLICRAHQL VHEGYKFMFD EKLVTVWSAP NYCYRCGNIA SIMVFKDVNT REPKLFRAVP DSERVIPPRT TTPYFL (1-305 aa encoded by B C006990)
靶标信息
Distinct DNA repair pathways minimize the consequences of mutagenic events. Reactive oxygen species (ROS) are highly reactive atoms with an unpaired electron that are conducive to double-strand DNA breaking events. Artemis, named after the Greek goddess for the protection of children, is one of the major proteins contributing to the preservation of double-strand breaks in DNA by cutting away the damaged parts of the DNA, which allows the strands to rejoin. Artemis is a single-strand-specific 5' to 3' exonuclease that forms a complex with the 469 kDa DNA-dependent protein kinase (DNA-PKcs). DNA-PKcs phosphorylates Artemis, and Artemis acquires endonucleolytic activity on 5' and 3' overhangs and hairpins. These activities are essential for V(D)J recombination and for the 5' and 3' overhang processing in nonhomologous DNA end joining.
仅用于科研。不用于诊断过程。未经明确授权不得转售。
生物信息学
蛋白别名: ANKRD33; FLJ34236; PP-V; PP6C; Protein phosphatase V; serine/threonine protein phosphatase catalytic subunit; Serine/threonine-protein phosphatase 6 catalytic subunit; unnamed protein product; UNQ5837
基因别名: 2310003C10Rik; PP6; PP6C; PPP6; PPP6C; Ppv
UniProt ID: (Human) O00743, (Rat) Q64620, (Mouse) Q9CQR6
Entrez Gene ID: (Human) 5537, (Rat) 171121, (Mouse) 67857